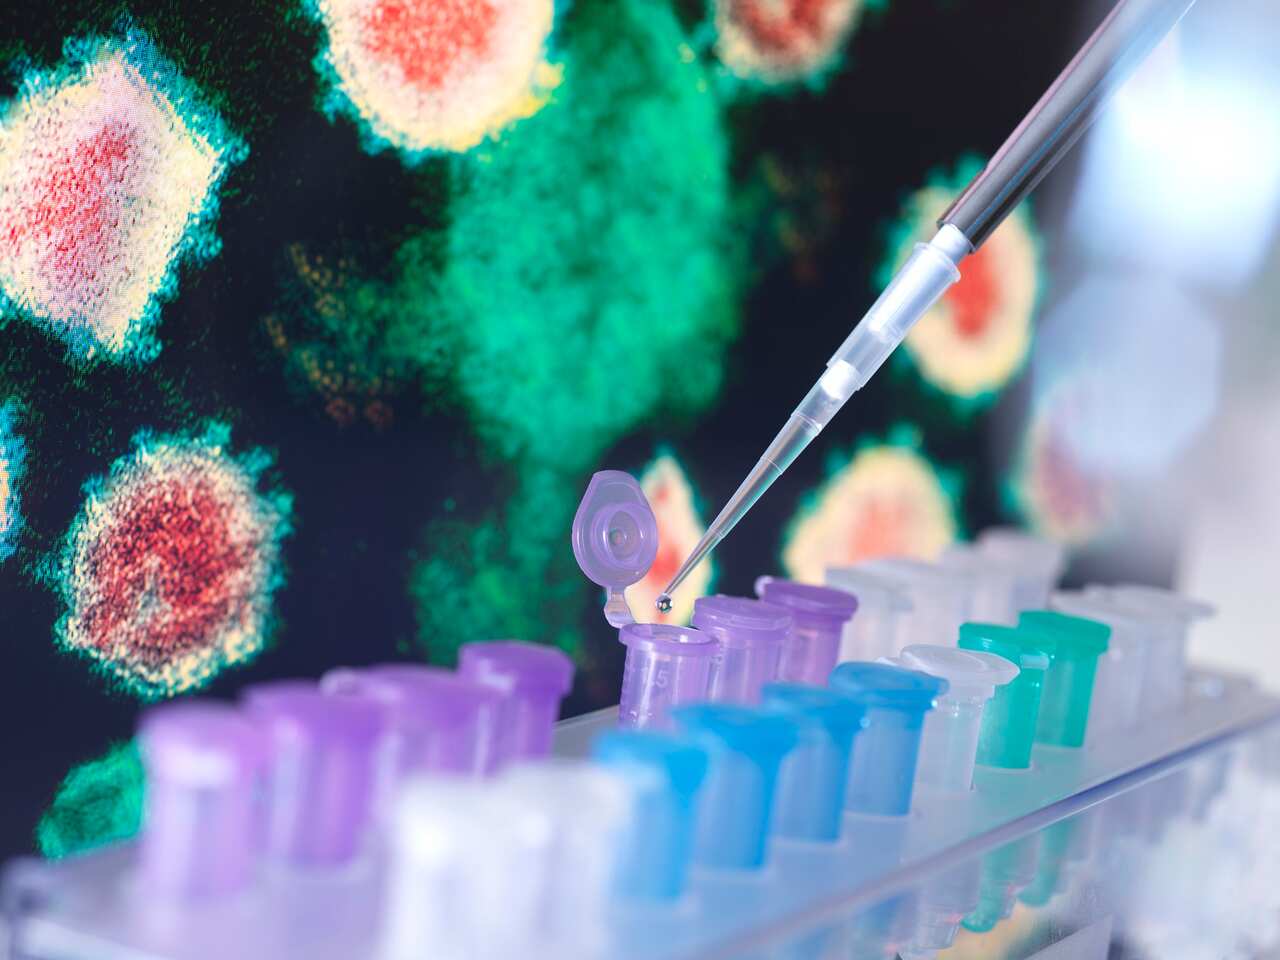
COVID-19

قالت الدكتورة أماني ناشد في حديثها مع SBS عربي24 أن المرضى عادة ما يحتارون في التمييز بين الزكام Cold أو الإنفلونزا Flu، لذلك أوضحت أن أعراض الزكام تتطور تدريجياً إلا أنه فيروس خفيف وعوارضه خفيفة كاحتقان الأنف وعادة ما يشفى المريض خلال أيام قليلة.
أما بالنسبة للإنفلونزا فهو فيروس مختلف تماماً عن الزكام بحيث أنه أشد وأكثر خطورة وتتمثل عوارضه بالصداع الشديد والحرارة وآلام الجسم وفقدان الشهية والخمول.
تحدث الإنفلونزا بشكل مفاجئ، فمن الممكن أن تكون بصحة جيدة وتتدهور صحتك خلال ساعات قليلة
أما فيما يخص الكورونا، فقد أضافت الدكتورة أماني أنه فيروس ثالث يختلف عن كل من فيروسي الزكام والإنفلونزا إلا أن أعراضه تتشابه إلى حد كبير مع أعراض الإنفلونزا.
أنا كدكتورة لا يمكنني التمييز بين الكورونا والإنفلونزا بسبب تشابه الأعراض إلا من خلال فحص المستضد السريع RAT test أو PCR.
كما نصحت بضرورة الاتصال بالطبيب إذا كان الشخص يعاني من هذه الأعراض الشديدة وإطلاعه على الخطوات التي قام بها لا سيما أن نتيجة فحص المستضد السريع لا تكون دقيقة دائماً حتى ينصحه الطبيب بما يجب فعله كخطوة تالية.

وشددت على ضرورة بقاء المريض في البيت حتى لا يساهم في انتشار الفيروسإلى أن يتم تشخيص الحالة.
وختمت الدكتورة أماني حديثها بوجوب أخذ لقاح الإنفلونزا حتى لو لم يحصل عليه الشخص من قبل لأن الوقاية خير من العلاج.
استمعوا إلى المقابلة كاملة في التسجيل الصوتي المرفق في أعلى الصفحة.




